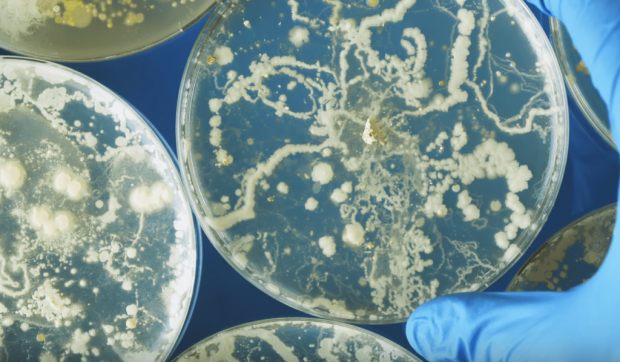

Think Twice Before Eating Leftover Pasta Because It Can Be Fatal
Let’s admit it, most of us are too lazy to cook a new meal every day. Moreover, sometimes we cook more food than we actually need and end up with a lot of leftovers that we can consume later. However, apparently, not all leftovers are as safe to eat as we initially thought.

1
This information was shared by the Journal of Clinical Microbiology. The concerns about eating leftovers became stronger after a 2008 news story about a college student who died short after eating their dinner. The case has since gained attention once again and gone viral. The student in the story decided to reheat a pasta bowl after his class was over. It’s unthinkable to die from eating leftover pasta, however, the student made a mistake since the pasta bowl had been left sitting out on the corner for a couple of days beforehand.
2
After he finished his meal, he went outside to participate in a sporting event. That was when the effects of eating the leftover pasta kicked in. The young man thought he had food poisoning, so he just laid down to sleep it off.
